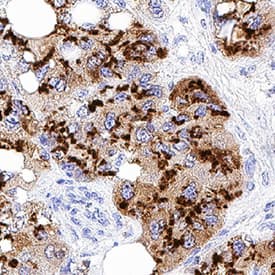
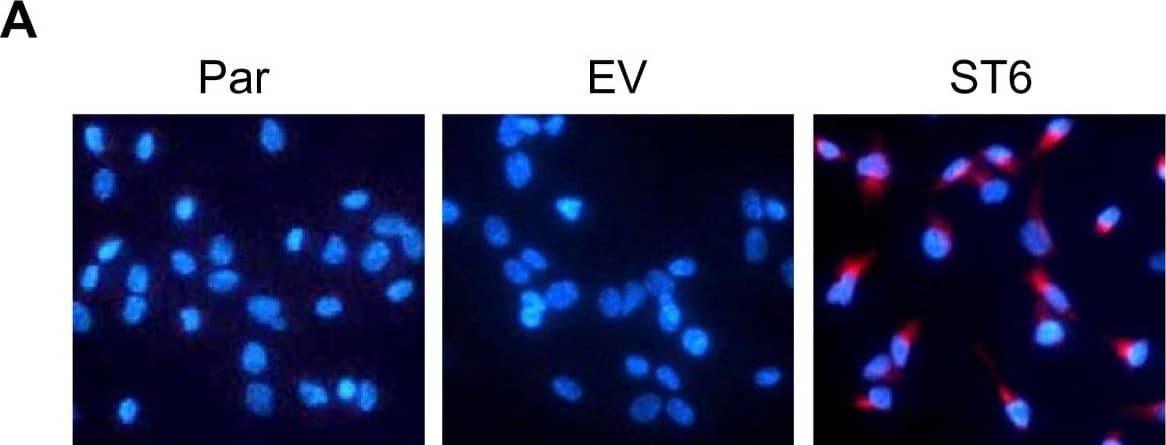
Detection of Human ST6 Gal Sialyltransferase 1/ST6GAL1/CD75 by Immunocytochemistry/Immunofluorescence

Human ST6 Gal Sialyltransferase 1/
ST6GAL1 Antibody
R&D Systems, part of Bio-Techne | Catalog # AF5924


Key Product Details
Validated by
Species Reactivity
Validated:
Cited:
Applications
Validated:
Cited:
Label
Antibody Source
Product Specifications
Immunogen
Lys27-Cys406
Accession # P15907
Specificity
Clonality
Host
Isotype
Scientific Data Images for Human ST6 Gal Sialyltransferase 1/ST6GAL1 Antibody
Detection of Human ST6 Gal Sialyltransferase 1/ST6GAL1 by Western Blot.
Western blot shows lysates of Daudi human Burkitt's lymphoma cell line. PVDF Membrane was probed with 1 µg/mL of Goat Anti-Human ST6 Gal Sialyltransferase 1/ST6GAL1 Antigen Affinity-purified Polyclonal Antibody (Catalog # AF5924) followed by HRP-conjugated Anti-Goat IgG Secondary Antibody (HAF019). A specific band was detected for ST6GAL1 at approximately 56 kDa (as indicated). This experiment was conducted under reducing conditions and using Immunoblot Buffer Group 8.ST6 Gal Sialyltransferase 1/ST6GAL1 in Human Liver.
ST6 Gal Sialyltransferase 1/ST6GAL1 was detected in immersion fixed paraffin-embedded sections of human liver using Goat Anti-Human ST6 Gal Sialyltransferase 1/ST6GAL1 Antigen Affinity-purified Polyclonal Antibody (Catalog # AF5924) at 0.3 µg/mL for 1 hour at room temperature followed by incubation with the Anti-Goat IgG VisUCyte™ HRP Polymer Antibody (VC004). Before incubation with the primary antibody, tissue was subjected to heat-induced epitope retrieval using Antigen Retrieval Reagent-Basic (CTS013). Tissue was stained using DAB (brown) and counterstained with hematoxylin (blue). Specific staining was localized to cytoplasm in hepatocytes. Staining was performed using our protocol for IHC Staining with VisUCyte HRP Polymer Detection Reagents.ST6 Gal Sialyltransferase 1/ST6GAL1 in Human Prostate.
ST6 Gal Sialyltransferase 1/ST6GAL1 was detected in immersion fixed paraffin-embedded sections of human prostate using Goat Anti-Human ST6 Gal Sialyltransferase 1/ST6GAL1 Antigen Affinity-purified Polyclonal Antibody (Catalog # AF5924) at 1 µg/mL for 1 hour at room temperature followed by incubation with the Anti-Goat IgG VisUCyte™ HRP Polymer Antibody (VC004). Before incubation with the primary antibody, tissue was subjected to heat-induced epitope retrieval using Antigen Retrieval Reagent-Basic (CTS013). Tissue was stained using DAB (brown) and counterstained with hematoxylin (blue). Specific staining was localized to cytoplasm in glandular epithelial cells. Staining was performed using our protocol for IHC Staining with VisUCyte HRP Polymer Detection Reagents.Applications for Human ST6 Gal Sialyltransferase 1/ST6GAL1 Antibody
Immunocytochemistry
Sample: Immersion fixed U266 human myeloma cell line (Positive) & RT-4 human urinary bladder transitional cell papilloma cell line (Negative)
Immunohistochemistry
Sample: Immersion fixed paraffin-embedded sections of human liver and immersion fixed paraffin-embedded sections of human prostate
Simple Western
Sample: Daudi human Burkitt's lymphoma cell line
Western Blot
Sample: Daudi human Burkitt's lymphoma cell line
Reviewed Applications
Read 1 review rated 5 using AF5924 in the following applications:
Formulation, Preparation, and Storage
Purification
Reconstitution
Formulation
Shipping
Stability & Storage
- 12 months from date of receipt, -20 to -70 °C as supplied.
- 1 month, 2 to 8 °C under sterile conditions after reconstitution.
- 6 months, -20 to -70 °C under sterile conditions after reconstitution.
Background: ST6 Gal Sialyltransferase 1/ST6GAL1
Sialic acid molecules attached to glycoproteins or glycosphingolipids play important roles in various biological processes such as immune recognition, pathogen infection, and cell adhesion (1). Sialyltransferases are key enzymes that regulate the cellular levels of sialic acid-containing molecules. Beta-galactosamide alpha‑2,6‑sialyltransferase 1 encoded by the ST6GAL1 gene is a type-II membrane protein localized in the trans-Golgi network and catalyzes 2,6-sialylation of Gal beta1,4‑GlcNAc structures on N-glycans (2). The enzyme is involved in the generation of the cell-surface carbohydrate determinants and differentiation antigens HB‑6, CD75, and CD76 (3). ST6GAL1 is highly expressed in the liver and also expressed in most other tissues to some extent (4). ST6GAL1 deficiency causes abnormalities in B-cell immunoreactivity (5). The expression and activity of ST6GAL1 are associated with tumor metastasis in breast (6) and colon (7) cancers. The majority of ST6GAL1 in the liver is cleaved and secreted into the serum (8) and may be used as a biomarker for hepatitis diseases (9).
References
- Varki, A. et al. (1999) Essentials of Glycobiology, Cold Spring Harbor Laboratory Press, pp195.
- Weinstein, J. et al. (1987) J. Biol. Chem. 262:17735.
- Bast, B.J. et al. (1992) J. Cell Biol. 116:423.
- Kitagawa, H. and J.C. Paulson (1994) J. Biol. Chem. 269:17872.
- Hennet, T. et al. (1998) Proc. Natl. Acad. Sci. USA 95:4504.
- Recchi, M.A. et al. (1998) Cancer Res. 58:4066.
- Dall’Olio, F. et al. (2001) Eur. J. Biochem. 268:5876.
- Weinstein, J. et al. (1987) J. Biol. Chem. 262:17735.
- Kitazume, S. et al. (2009) Glycobiology 19:479.
Long Name
Alternate Names
Gene Symbol
UniProt
Additional ST6 Gal Sialyltransferase 1/ST6GAL1 Products
- All Products for ST6 Gal Sialyltransferase 1/ST6GAL1
- ST6 Gal Sialyltransferase 1/ST6GAL1 cDNA Clones
- ST6 Gal Sialyltransferase 1/ST6GAL1 ELISA Kits
- ST6 Gal Sialyltransferase 1/ST6GAL1 Lysates
- ST6 Gal Sialyltransferase 1/ST6GAL1 Primary Antibodies
- ST6 Gal Sialyltransferase 1/ST6GAL1 Proteins and Enzymes
Product Documents for Human ST6 Gal Sialyltransferase 1/ST6GAL1 Antibody
Product Specific Notices for Human ST6 Gal Sialyltransferase 1/ST6GAL1 Antibody
For research use only